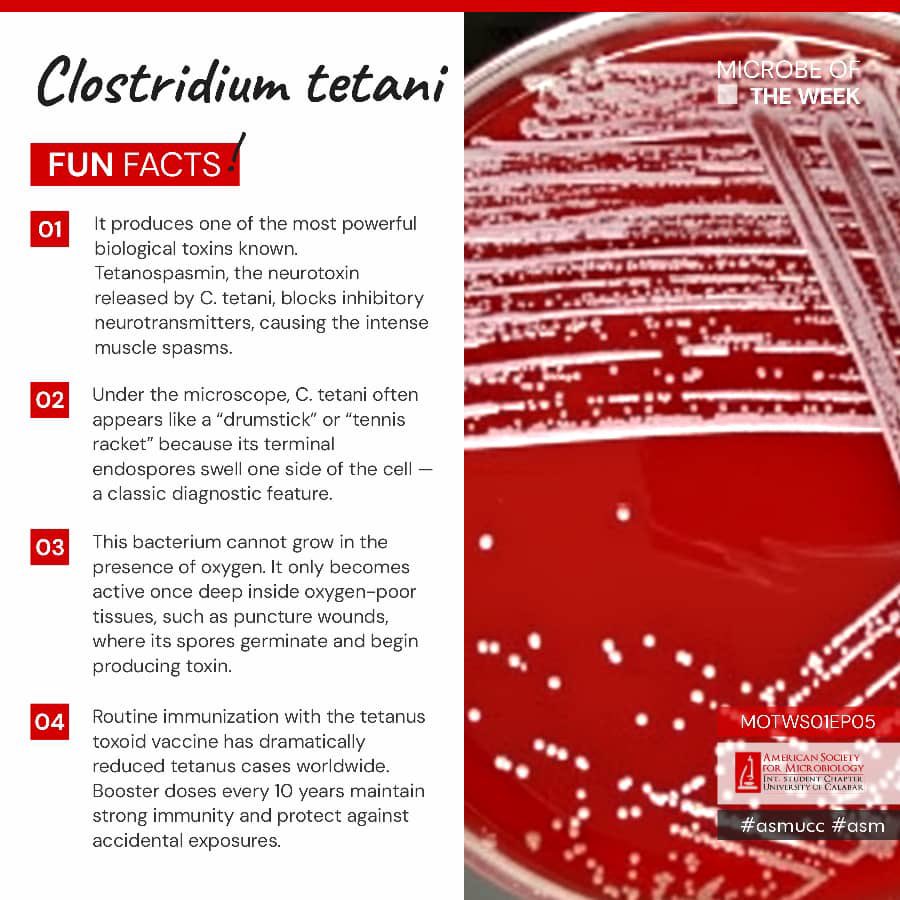
ASMUCC's tweet image. 🔬 Microbe of the Week: Clostridium tetani 🦠

Say hello 👋🏽 to Clostridium tetani — the silent but powerful microbe responsible for the disease tetanus. 🧫
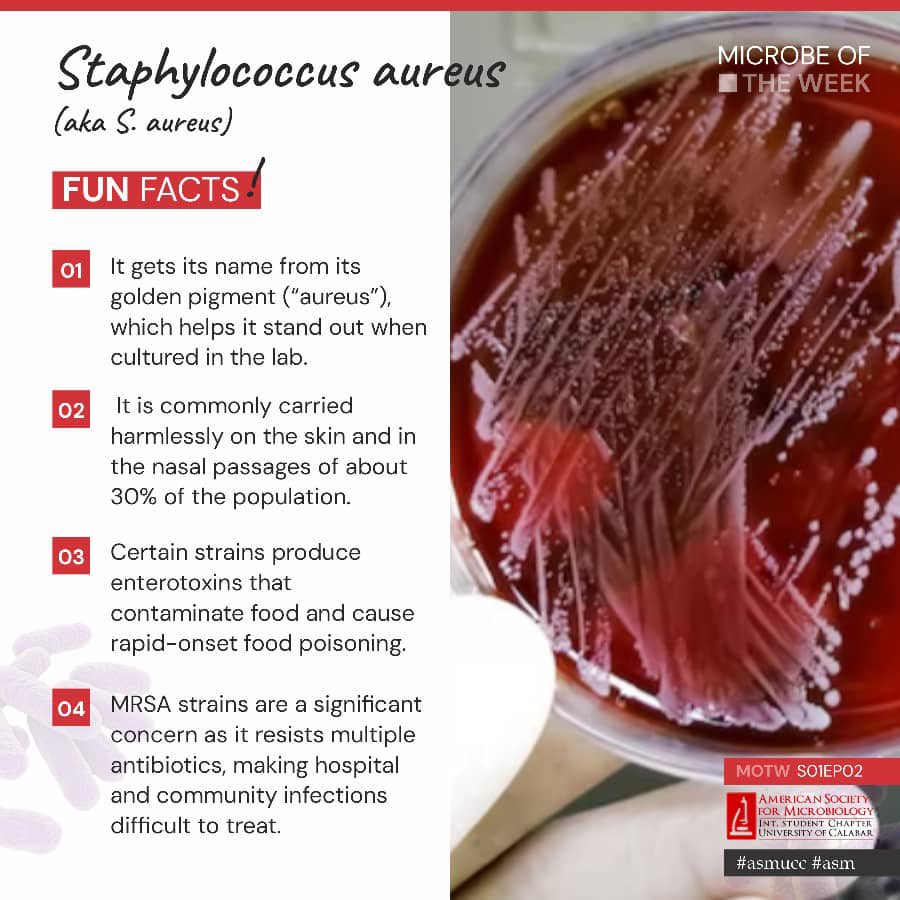
ASMUCC's tweet image. ASM UCC series

🔬 Microbe of the Week: Staphylococcus aureus

Here’s Staphylococcus aureus 🦠 — the golden staph that lives on our skin and in our noses.

내가 좋아할 만한 콘텐츠
🔬 Microbe of the Week: Clostridium tetani 🦠 Say hello 👋🏽 to Clostridium tetani — the silent but powerful microbe responsible for the disease tetanus. 🧫
🌍💧 GLOBAL HANDWASHING DAY 2025. DAY 2 Theme: The Power of Clean Hands Focus: The Science Behind Clean Hands Our hands are powerful tools, but they can also spread harmful germs if not properly washed.

ASM UCC series 🔬 Microbe of the Week: Staphylococcus aureus Here’s Staphylococcus aureus 🦠 — the golden staph that lives on our skin and in our noses.
"Exciting news! 🤝✨ We’re thrilled to share that the American Society for Microbiology Int. Student Chapter University of Calabar has officially teamed up with the American Society for Microbiology Int. Student Chapter Rosiere and Affiliates! 🇳🇬🤝🇨🇲 🌍💡

VIDEO: Mr. Peter Obi visited the University of Calabar this morning and donated ₦20 million to the Faculty of Dentistry to support the 400 dental students who are being threåtenéd with unfair expulsion and withdrawal from the university. Please share!!!
VERY GOOD NEWS!!!! I’m really happy to announce this. After I made an open letter to @PeterObi about the dental student of UniCal, he tweeted about it and he has done far more than we can imagine!!! @PeterObi has just given 20million naira to the Faculty of Dentistry in…




What legacy will you be remembered for?
#SaveDentalStudentsOfUnical #SaveDentalStudentsOfUnical #SaveDentalStudentsOfUnical #SaveDentalStudentsOfUnical #SaveDentalStudentsOfUnical #SaveDentalStudentsOfUnical #SaveDentalStudentsOfUnical #SaveDentalStudentsOfUnical #SaveDentalStudentsOfUnical Pls help lend your voice.
The VC University of Calabar is planning to expel 300 dental students after giving them an admission and many of them spending up to 6years in school. Reason: The university admitted more students than they are legally allowed to. The VC told them to go and “learn trade”. Pls…




The injustice done today to the dentistry students in university of Calabar can happen to any other students in the same university or elsewhere. That a university loses accreditation is NOT the student’s problem. The VC of UniCAL is a callous cruel human being for telling over…
We know Nobody will be sacked, We know nobody will be punished, We know no investigation into why 300 dental students were admitted into the university of Calabar when the quota is 10, We know the VC will not be questioned, We know nobody will look into who benefited from it,…
Dear Girl Child You are Loved You are Strong You are Smart You are the Future Happy International Day Of The Girl Child #InternationalDayoftheGirl2024 #ssdpunical #ssdpintl #SupportDontPunish #OverdoseDay #WADPN #drugpolicyadvocacy #DrugPolicyReform

#JMedMicro is looking for a Senior Editor to shape our AMR content and foster community engagement. Find out more and apply by 14 October here: microb.io/jobs #PublishingForTheCommunity
If APC members accuse you of anything, they have either done it, doing it or are about to do it. I’m curious why @DOlusegun is angry that Nigerians want to ask him some questions about the protests. Why is he threatening Nigerians, yet he wanted to end Nigeria few years ago?




United States 트렌드
- 1. Cyber Monday 50.1K posts
- 2. TOP CALL 11.8K posts
- 3. Admiral Bradley 2,104 posts
- 4. GreetEat Corp. N/A
- 5. Shakur 6,423 posts
- 6. Adam Thielen 2,764 posts
- 7. #Rashmer 19.4K posts
- 8. #GivingTuesday 3,079 posts
- 9. Alina Habba 35.5K posts
- 10. Hartline 3,006 posts
- 11. MSTR 29.6K posts
- 12. Check Analyze N/A
- 13. Token Signal 3,827 posts
- 14. #IDontWantToOverreactBUT 1,515 posts
- 15. Marty Supreme 3,540 posts
- 16. UCLA 7,302 posts
- 17. Toosii N/A
- 18. Shopify 5,016 posts
- 19. Clarie 3,969 posts
- 20. LA PIJAMADA VIRAL 56.1K posts
내가 좋아할 만한 콘텐츠
-
 Eastbrooks🌊
Eastbrooks🌊
@EasternBrooks -
 Ego oyibo
Ego oyibo
@luchisgold -
 Soli
Soli
@solibayo -
 Jonatex Iktex
Jonatex Iktex
@Jonatex247 -
 Mahfuz
Mahfuz
@mahfuxz -
 Otunba👑😈
Otunba👑😈
@bolexino33080 -
 Cleavergerrard
Cleavergerrard
@MondayEhis2 -
 Tamaraebi Deborah Engbi
Tamaraebi Deborah Engbi
@TamaraebiEngbi -
 Nicholas Emmanuel
Nicholas Emmanuel
@techieEmma -
 Iykemane
Iykemane
@iykemane -
 NiceGuy 🃏
NiceGuy 🃏
@Jxt_charles -
 DammyVerse 🌌💎
DammyVerse 🌌💎
@VibeWithDammy -
 Bube!
Bube!
@ClareAgaba_ -
 Bede
Bede
@Bede72158361 -
 ONIDA ⚔️
ONIDA ⚔️
@Afolabi48670720
Something went wrong.
Something went wrong.























































































































